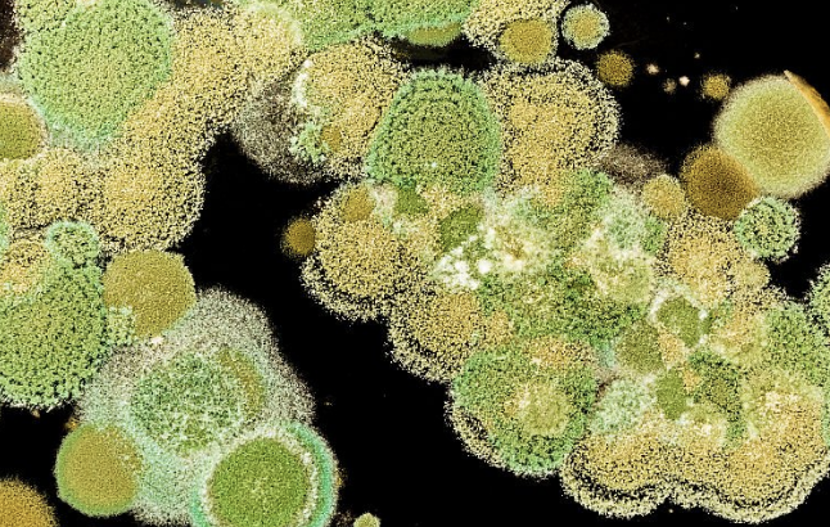

天天听健康 此物已被纳入伤肝“黑榜 ”医生呼吁:不想肝脏烂掉 1食材趁早少吃

文章图片

文章图片
文章图片

文章图片

韩女士今年56岁 , 丈夫早逝 , 自己一直和女儿相依为命 , 好在女儿学习努力 , 考上了重点大学 , 今年就要毕业了 。 她觉得自己马上就要苦尽甘来 , 幸福生活的也就要开始了 。
但是前段时间韩女士发现自己的右上腹疼的厉害 , 一开始觉得是简单的肚子疼 , 喝点热水暖暖就好了 , 没多在意 , 但是过了好大一会还没有好转 , 最后忍受不住疼痛 , 晕了过去 。
邻居发现后赶紧拨打了急救电话 , 把韩女士送往了医院 。 在医院经过一系列的检查后发现 , 韩女士已经是肝癌晚期了 , 韩女士及家人都不敢相信 , 怎么会那么突然地得了这个病 。
医生询问躺在病床上的韩女士 , 之前就没有发现自己身体有什么异样吗?韩女士回忆后说道 , 半年前她就常感到浑身乏力、到饭点了还没有胃口 , 还会出现恶心、呕吐的情况 。 那时觉得是自己的胃病犯了 , 没当回事 。 医生叹息道 , 半年前你的身体就在提醒你了 , 那时候你不重视 , 拖到现在变得更严重了 。
韩女士听后感到十分后悔 , 想着要是当时去医院检查一下说不定就不会变那么严重了 。
医生提醒:吃一口就是在肝脏上挖孔 , 不想肝脏烂掉 , 1食材趁早远离
说道韩女士患上肝癌的原因 , 医生也是了解后才发现 。 原来 , 韩女士平时工作比较忙 , 平时没有太多时间去菜市场采购食材 , 所以每次去就会采购好多天的食材 。 食材较多 , 一时也吃不完 , 经常会出现发霉的情况 , 因为她平时比较节俭 , 也不舍得扔 , 觉得洗洗还能吃 。
然而就是因为她经常吃霉变的食材 , 才为患上了肝癌埋下隐患 。
研究显示 , 霉变的食物为细菌创造了极佳的生长繁殖环境 , 黄曲霉菌就喜欢隐藏在这些霉变食物中 , 其产生的黄曲霉毒素是致癌物质 , 摄入人体就会加大器官癌变的风险 , 危害人体健康 。
平时家中的粮油食材一定要存放妥当 , 防止霉变变质 。 一旦发现食材霉变变质就需要停止食用 , 以免以小失大 , 对身体造成严重危害 。
除此之外 , 此物也是肝癌“推手”趁早远离
剩菜剩饭
冰箱也是细菌首选的生存环境之一 , 平时留下的剩菜剩饭多数人都会选择放在冰箱里 , 下次热一热接着吃 , 如果加热不到够或是不加热 , 上面的细菌就不能被有效清除 , 人食用就会把病菌带入体内 , 加重肝脏负担 。 剩菜剩饭存放的时间过长 , 会产生亚硝酸盐 , 这种物质会损坏肝细胞 , 增加患癌风险 , 极易引发肝硬化和肝癌的病症 。
医生建议:要想肝脏变好 , 日常3事要多做
1、补充肝脏营养物质
2、豆腐
豆腐富含充足的蛋白质 , 对提高人体自身免疫力及抵抗力有很好的效果 , 能够促进身体毒素的排出 。 多吃豆腐还能起到美容养颜的作用 , 使皮肤富有光泽变得光滑细腻 。 同时豆腐脂肪含量低 , 吃多了也不会长胖 。 不会加重肝脏分解脂肪的负担 。
经验总结扩展阅读
- 什么家有柯基:柯基幼犬可以吃什么 小柯基吃什么又营养又健康?
- 生活听语兮:大声说爱你,喜欢就大胆说出来
- 把公司当家每天10点下班回家,老板也天天夸,年终奖却比别人少
- 东西方健康艳丽才是最好的,东西方的审美,是有很大差别的
- 失恋 你讲话好好听哦 (??????)?
- 运动 咖啡真的不健康吗?到底能不能减肥?
- 人参“减法”更健康,参谷无硅油健康洗护挑战三大极致体验
- 化妆品 “美男刘海”帅气十足,奋豆“新皇登基”垂帘听政,阿星:太猛了
- 血糖 糖尿病人建议要减肥,那如何才能健康安全的减肥呢?不妨看看!
- 进行肌肤更新的两大关键词
